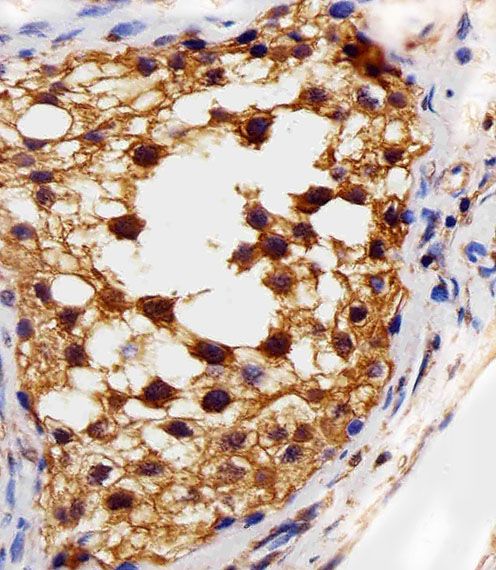
产品封面图

相关产品推荐更多 >
万千商家帮你免费找货
0 人在求购买到急需产品
- 详细信息
- 文献和实验
- 技术资料
- 免疫原:
Purified His-tagged VEGFR3 protein
- 亚型:
IgG2a
- 形态:
Liquid
- 保存条件:
Store as concentrated solution. Centrifuge briefly prior to opening vial. For short-term storage (1-2 weeks), store at 4ºC. For long-term storage, aliquot and store at -20ºC or below. Avoid multiple freeze-thaw cycles.
- 克隆性:
Monoclonal
- 标记物:
Unconjugated
- 适应物种:
Human, Rat
- 保质期:
12 months from the shipping date of the product.
- 抗原来源:
Human
- 目录编号:
GTX17567
- 级别:
Primary Antibodies
- 库存:
Available
- 供应商:
GeneTex
- 宿主:
Mouse
- 应用范围:
WB, IHC-P, FACS
- 浓度:
Batch dependent (Please refer to the vial label for the specific concentration.)
- 靶点:
VEGF Receptor 3
- 抗体英文名:
VEGF Receptor 3 antibody [818CT12.1.1]
- 抗体名:
VEGF Receptor 3 抗体 [818CT12.1.1]
- 规格:
400 μl
IHC-P analysis of human kidney tissue section using GTX17567 VEGF Receptor 3 antibody [818CT12.1.1].
Dilution : 1:25
IHC-P analysis of rat kidney tissue section using GTX17567 VEGF Receptor 3 antibody [818CT12.1.1].
Dilution : 1:25
FACS analysis of HUVEC cells using GTX17567 VEGF Receptor 3 antibody [818CT12.1.1].
Green : Primary antibody
Blue : Isotype control
Dilution : 1:25
IHC-P analysis of human testis tissue section using GTX17567 VEGF Receptor 3 antibody [818CT12.1.1].
Dilution : 1:25
WB analysis of various samples using GTX17567 VEGF Receptor 3 antibody [818CT12.1.1].
Lane 1 : 293 whole cell lysate
Lane 2 : A549 whole cell lysate
Loading : 35μg per lane
风险提示:丁香通仅作为第三方平台,为商家信息发布提供平台空间。用户咨询产品时请注意保护个人信息及财产安全,合理判断,谨慎选购商品,商家和用户对交易行为负责。对于医疗器械类产品,请先查证核实企业经营资质和医疗器械产品注册证情况。
文献和实验PriCells: Primary cells culture with supplement of vascular endothelial growth factor (VEGF)
-1 is less well-defined, although it is thought to modulate VEGFR-2 signaling. Another function of VEGFR-1 may be to act as a dummy/decoy receptor, sequestering VEGF from VEGFR-2 binding (this appears to be particularly important during vasculogenesis in the embryo).
【翻译】Development trends for monoclonal antibody cancer therapeutics
in the mid- to late 1980s (Refs 12–14). In addition, human mAbs derived from phage display and transgenic mice became available in the 1990s (Refs 15, 16). It should be noted that human mAbs were also made from human hybridomas, but this production method
secondary antibody review -- data from 99 publications
cytometry used as a control to detect cell responses targeted antigen 7 Alexa Fluor 488 7 Cy3 8 goat IgG Alexa Fluor 488 1:2000 detect antibody binding in human embryonic kidney 293T cells Invitrogen 9 donkey
技术资料暂无技术资料 索取技术资料

![Histone H3K9me3S10ph (Tri-methyl Lys9 / phospho Ser10) antibody [RM162]](https://img1.dxycdn.com/2022/0328/682/1680677773343400453-14.jpg!wh200)

![Survivin antibody [2D9]](https://img1.dxycdn.com/2022/0328/197/0011965504188500453-14.jpg!wh200)

![ARG2 antibody [AT7F8]](https://img1.dxycdn.com/2022/0328/065/5027544876360800453-14.jpg!wh200)
